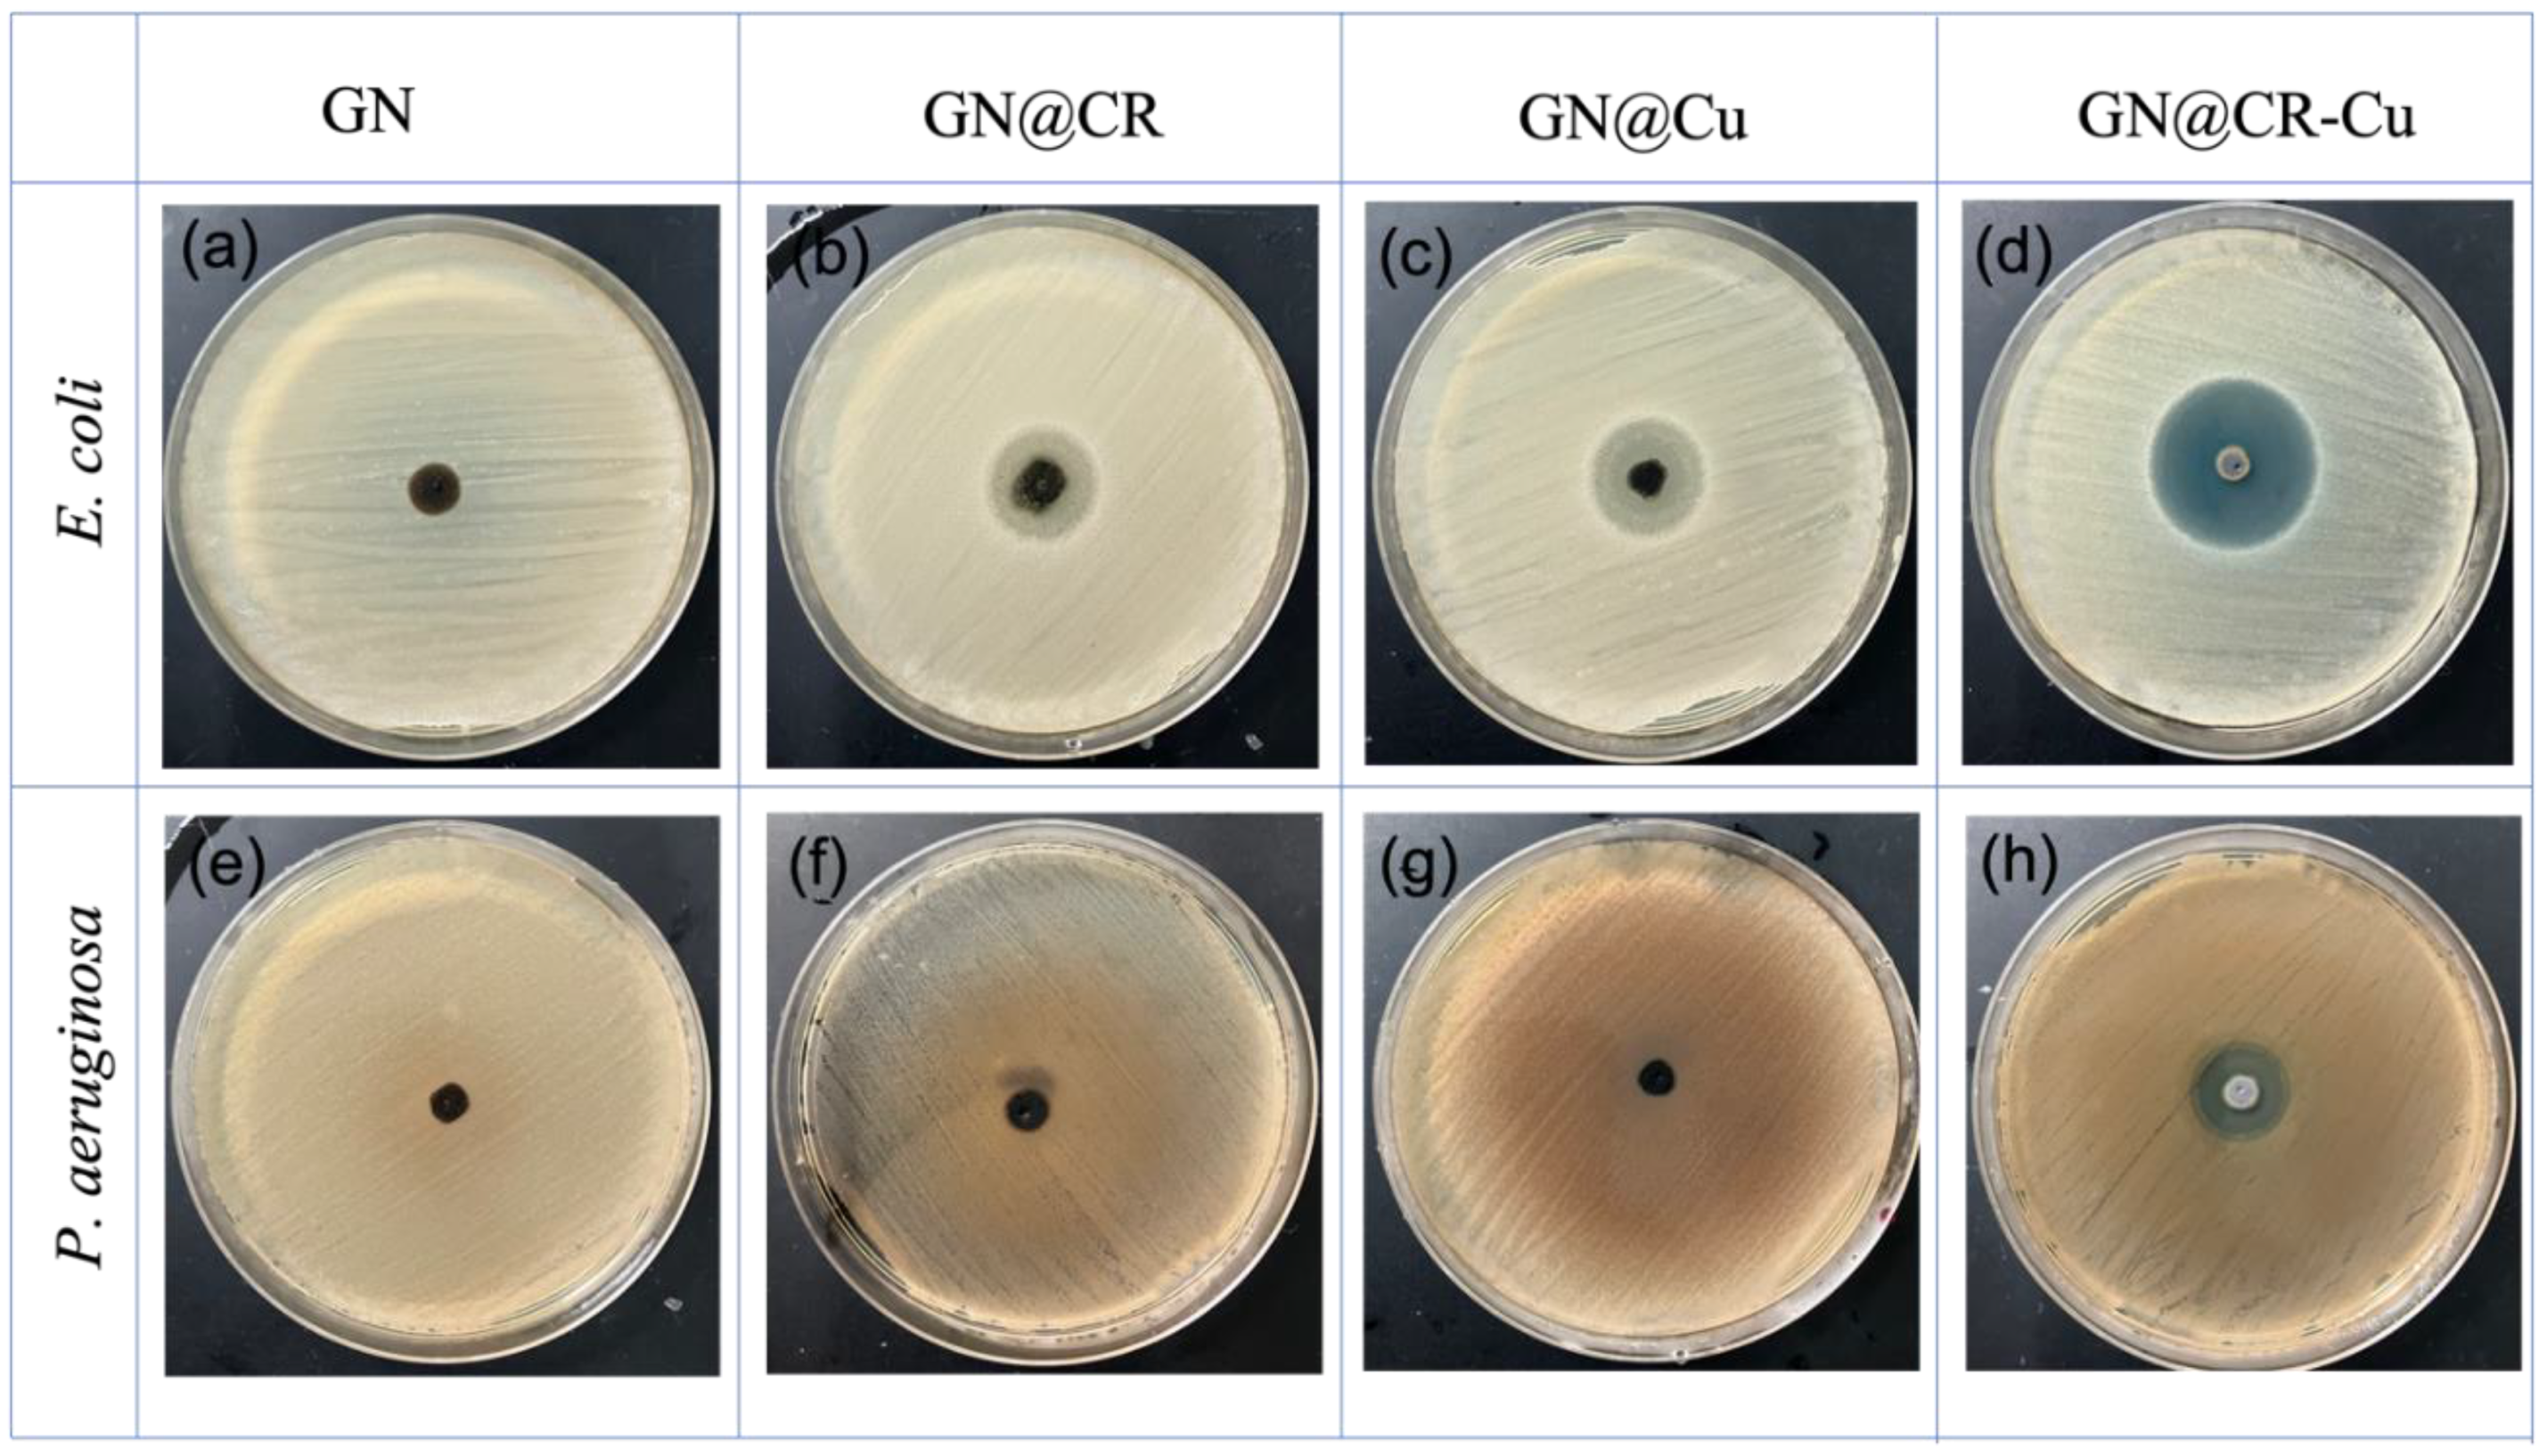
Molecules 28 02814 g006
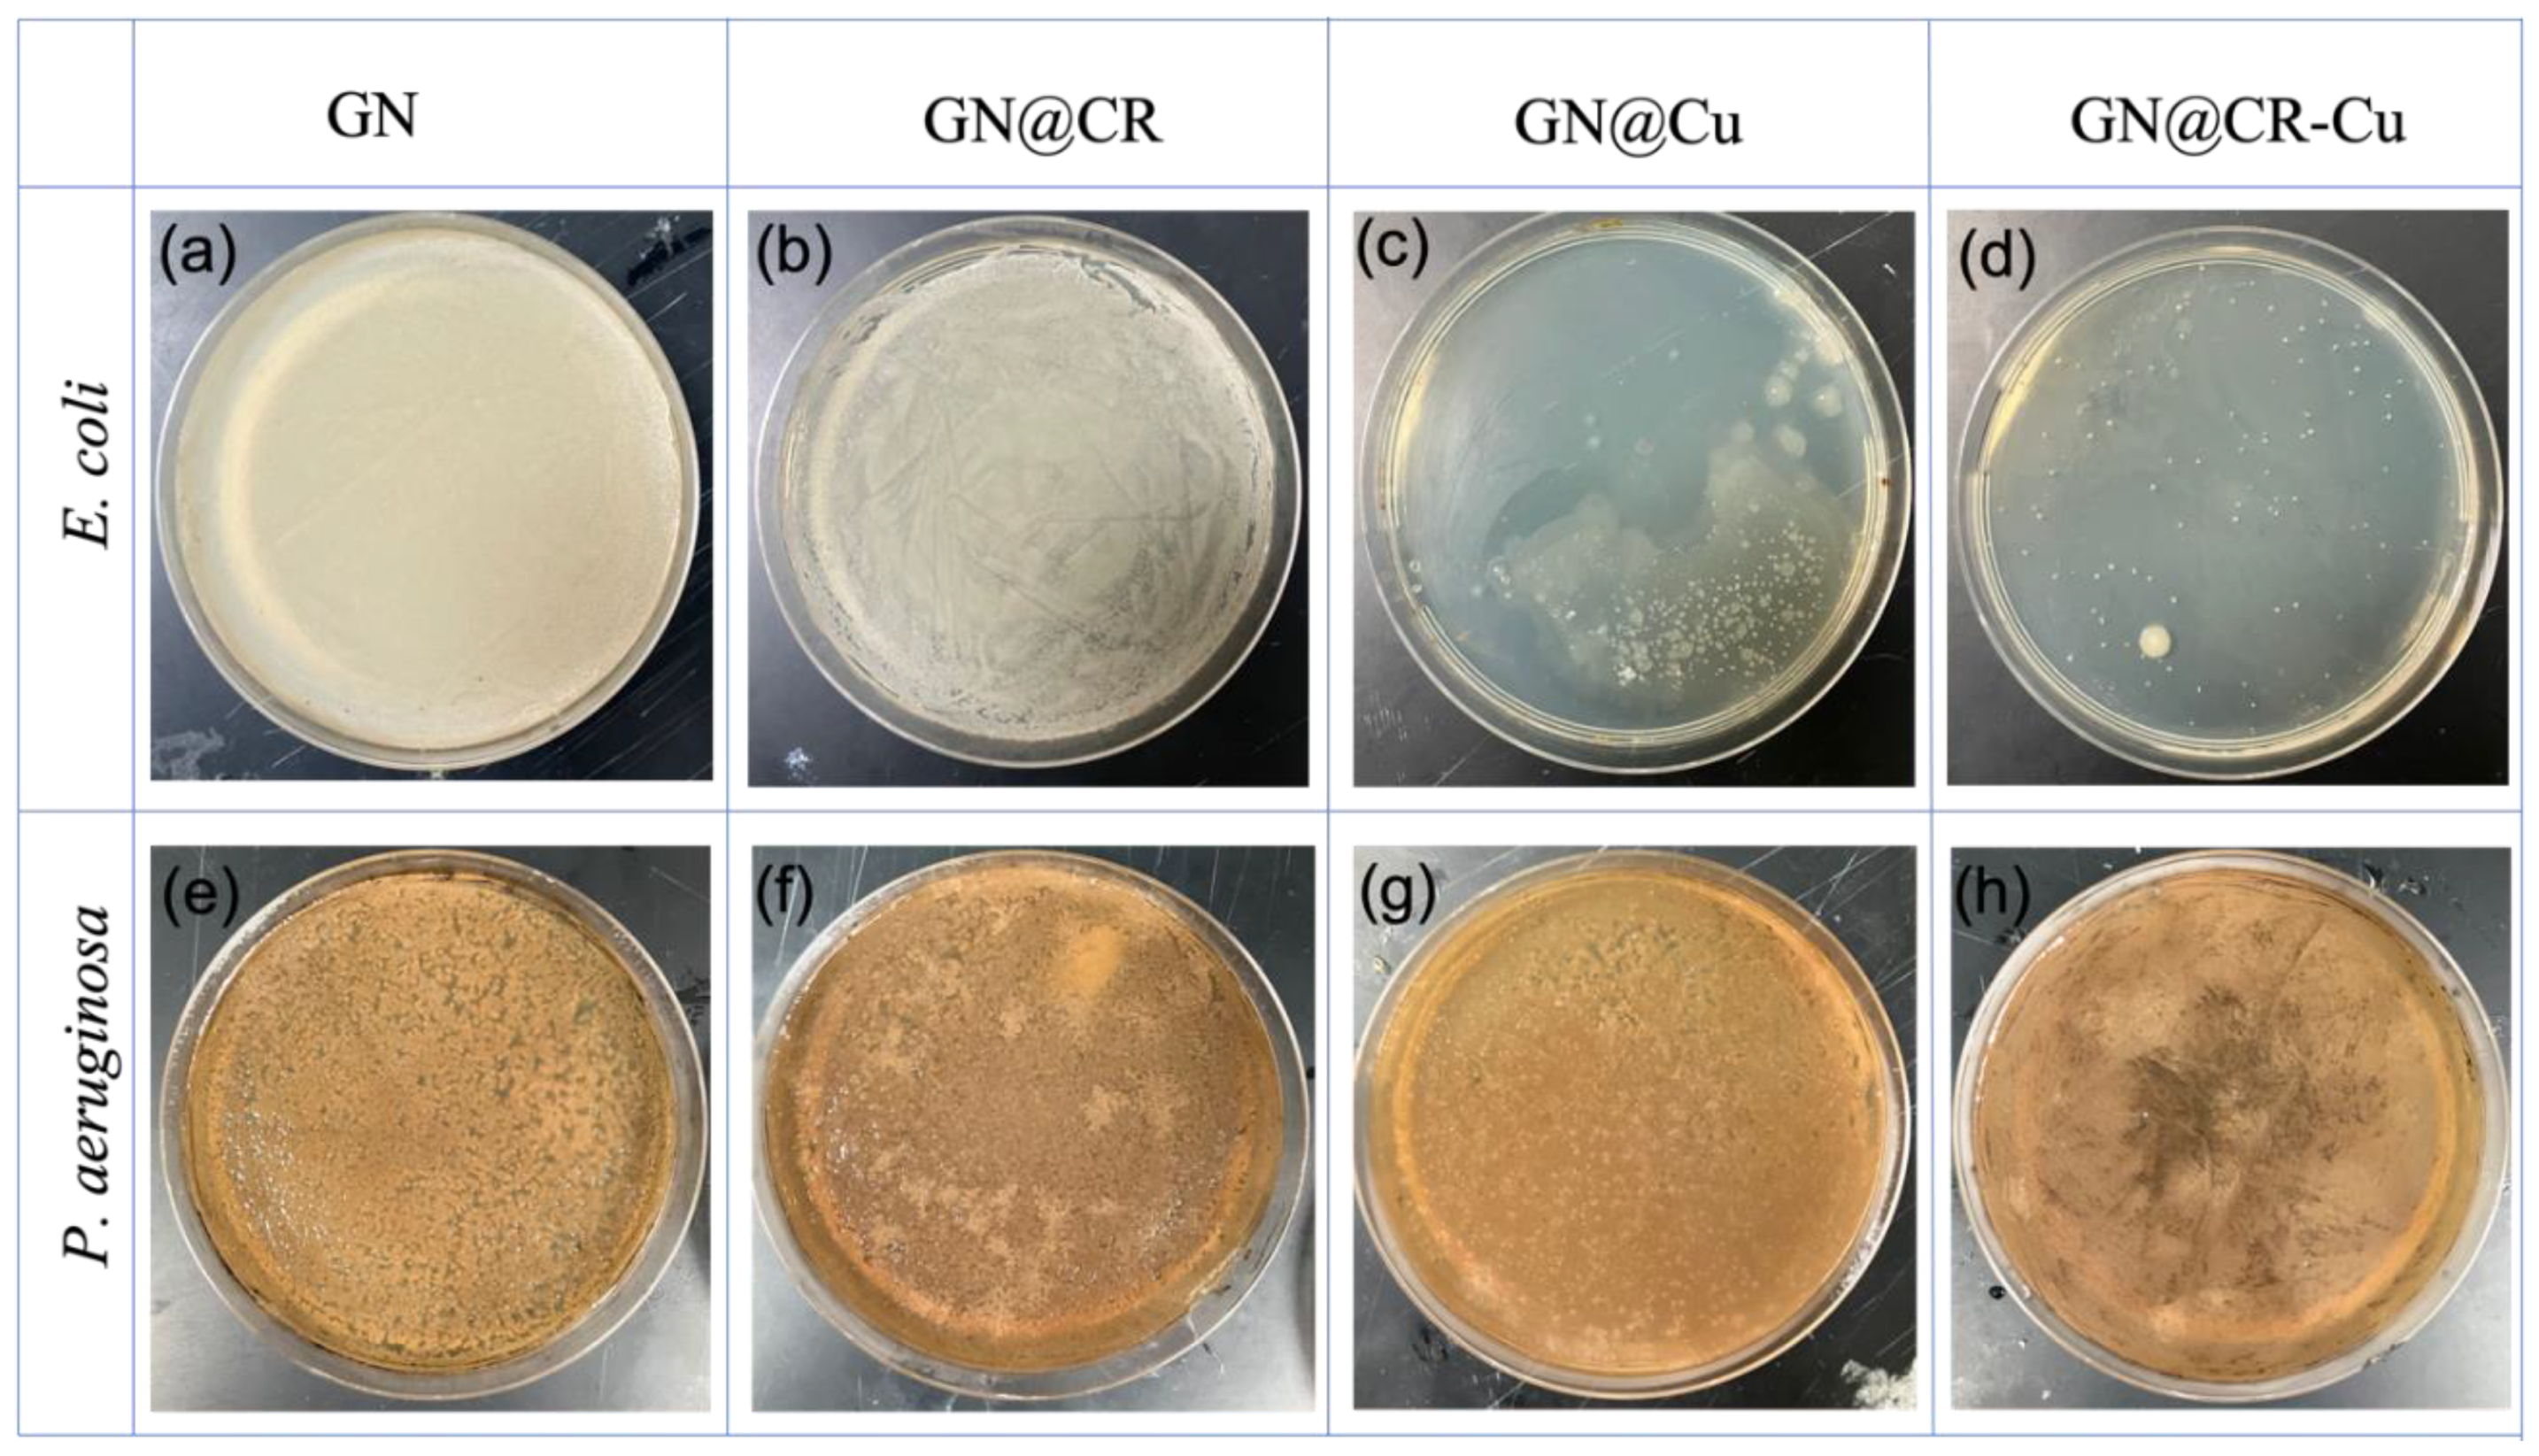
Molecules 28 02814 g007

Graphene@Curcumin-Copper Paintable Coatings for the Prevention of Nosocomial Microbial Infection
Abstract
1. Introduction
2. Results and Discussion
2.1. Morphological Analysis
2.2. X-ray Photoelectron Spectroscopy (XPS)
2.3. Antibacterial Performance of GN@CR-Cu Composite
3. Materials and Methods
3.1. Materials
3.1.1. Synthesis of Cu and GO@CR-Cu Suspension
3.1.2. Preparation of GO@CR-Cu Slurry
3.1.3. Characterization
3.2. Assessment of Antibacterial Activity of GN@CR-Cu Composite
3.2.1. Zone Inhibition Assay
3.2.2. MIC and MBC of GN@CR-Cu Composite
3.2.3. Bacterial Survivability with Nanomaterials
3.3. Imaging of Bacterial Growth Inhibition by SEM
4. Conclusions
Supplementary Materials
Author Contributions
Funding
Institutional Review Board Statement
Informed Consent Statement
Data Availability Statement
Conflicts of Interest
References
- Carrascosa, C.; Raheem, D.; Ramos, F.; Saraiva, A.; Raposo, A. Microbial Biofilms in the Food Industry-A Comprehensive Review. Int. J. Environ. Res. Public Health 2021, 18, 2014. [Google Scholar] [CrossRef] [PubMed]
- Lan, X.; Zhang, H.; Qi, H.; Liu, S.; Zhang, X.; Zhang, L. Custom-design of triblock protein as versatile antibacterial and biocompatible coating. Chem. Eng. J. 2023, 454, 140185. [Google Scholar] [CrossRef]
- Birkett, M.; Dover, L.; Lukose, C.C.; Zia, A.W.; Tambuwala, M.M.; Serrano-Aroca, A. Recent Advances in Metal-Based Antimicrobial Coatings for High-Touch Surfaces. Int. J. Mol. Sci. 2022, 23, 1162. [Google Scholar] [CrossRef]
- Yousefi, M.; Dadashpour, M.; Hejazi, M.; Hasanzadeh, M.; Behnam, B.; de la Guardia, M.; Shadjou, N.; Mokhtarzadeh, A. Anti-bacterial activity of graphene oxide as a new weapon nanomaterial to combat multidrug-resistance bacteria. Mater. Sci. Eng. C 2017, 74, 568–581. [Google Scholar] [CrossRef] [PubMed]
- Sawangphruk, M.; Srimuk, P.; Chiochan, P.; Sangsri, T.; Siwayaprahm, P. Synthesis and antifungal activity of reduced graphene oxide nanosheets. Carbon 2012, 50, 5156–5161. [Google Scholar] [CrossRef]
- Ebrahimi, M.; Asadi, M.; Akhavan, O. Graphene-based Nanomaterials in Fighting the Most Challenging Viruses and Immunogenic Disorders. ACS Biomater. C Sci. Eng. 2022, 8, 54–81. [Google Scholar] [CrossRef]
- Mohammed, H.; Kumar, A.; Bekyarova, E.; Al-Hadeethi, Y.; Zhang, X.; Chen, M.; Ansari, M.S.; Cochis, A.; Rimondini, L. Antimicrobial mechanisms and effectiveness of graphene and graphene-functionalized biomaterials. A scope review. Front. Bioeng. Biotechnol. 2020, 8, 465. [Google Scholar] [CrossRef]
- Roy, S.; Sarkhel, S.; Bisht, D.; Hanumantharao, S.N.; Rao, S.; Jaiswal, A. Antimicrobial mechanisms of biomaterials: From macro to nano. Biomater. Sci. 2022, 10, 4392–4423. [Google Scholar] [CrossRef]
- Kumar, P.; Huo, P.; Zhang, R.; Liu, B. Antibacterial properties of graphene-based nanomaterials. Nanomaterials 2019, 9, 737. [Google Scholar] [CrossRef]
- Akhavan, O.; Ghaderi, E.; Esfandiar, A. Wrapping bacteria by graphene nanosheets for isolation from environment, reactivation by sonication, and inactivation by near-infrared irradiation. Phys. Chem. B 2011, 115, 6279–6288. [Google Scholar] [CrossRef]
- Pham, V.T.H.; Truong, V.K.; Quinn, M.D.J.; Notley, S.M.; Guo, Y.; Baulin, V.A.; Kobaisi, M.A.; Crawford, R.J.; Ivanova, E.P. Graphene Induces Formation of Pores That Kill Spherical and Rod-Shaped Bacteria. ACS Nano 2015, 9, 8458–8467. [Google Scholar] [CrossRef]
- Jeong, J.; Kim, J.Y.; Yoon, J. The Role of Reactive Oxygen Species in the Electrochemical Inactivation of Microorganisms. Environ. Sci. Technol. 2006, 40, 6117–6122. [Google Scholar] [CrossRef] [PubMed]
- Azam, A.; Ahmed, A.; Oves, M.; Khan, M.; Memic, A. Size-dependent antimicrobial properties of CuO nanoparticles against Gram-positive and -negative bacterial strains. Int. J. Nanomed. 2012, 7, 3527–3535. [Google Scholar] [CrossRef]
- Akhavan, O.; Ghaderi, E. Cu and CuO nanoparticles immobilized by silica thin films as antibacterial materials and photocatalysts. Surf. Coat. Technol. 2010, 205, 219–223. [Google Scholar] [CrossRef]
- Azam, A.; Ahmed, A.; Oves, M.; Khan, M.S.; Habib, S.S.; Memic, A. Antimicrobial activity of metal oxide nanoparticles against Gram-positive and Gram-negative bacteria: A comparative study. Int. J. Nanomed. 2012, 7, 6003–6009. [Google Scholar] [CrossRef] [PubMed]
- Hasan, A.; Morshed, M.; Memic, A.; Hassan, S.; Webster, T.J.; Marei, H.E.-S. Nanoparticles in tissue engineering: Applications, challenges and prospects. Int. J. Nanomed. 2018, 13, 5637–5655. [Google Scholar] [CrossRef]
- Salah, N.; Habib, S.; Khan, Z.H.; Memic, A.; Azam, A.; Alarfaj, E.; Zahed, N.; Al-Hamedi, S. High-energy ball milling technique for ZnO nanoparticles as antibacterial material. Int. J. Nanomed. 2011, 6, 863–869. [Google Scholar] [CrossRef]
- Al-Amri, S.; Ansari, M.S.; Rafique, S.; Aldhahri, M.; Rahimuddin, S.; Azam, A.; Memic, A. Ni Doped CuO Nanoparticles: Structural and Optical Characterizations. Curr. Nanosci. 2015, 11, 191–197. [Google Scholar] [CrossRef]
- Abdullah, T.; Qurban, R.O.; Bolarinwa, S.O.; Mirza, A.A.; Pasovic, M.; Memic, A. 3D Printing of Metal/Metal Oxide Incorporated Thermoplastic Nanocomposites With Antimicrobial Properties. Front. Bioeng. Biotechnol. 2020, 8, 568186. [Google Scholar] [CrossRef]
- Salah, N.; Alfawzan, A.M.; Allafi, W.; Baghdadi, N.; Saeed, A.; Alshahrie, A.; Al-Shawafi, W.M.; Memic, A. Size-controlled, single-crystal CuO nanosheets and the resulting polyethylene–carbon nanotube nanocomposite as antimicrobial materials. Polym. Bull. 2021, 78, 261–281. [Google Scholar] [CrossRef]
- Mathews, S.; Hans, M.; Mücklich, F.; Solioz, M. Contact Killing of Bacteria on Copper Is Suppressed if Bacterial-Metal Contact Is Prevented and Is Induced on Iron by Copper Ions. Appl. Environ. Microbiol. 2013, 79, 2605–2611. [Google Scholar] [CrossRef]
- Parra, A.; Toro, M.; Jacob, R.; Navarrete, P.; Troncoso, M.; Figueroa, G.; Reyes-Jara, A. Antimicrobial effect of copper surfaces on bacteria isolated from poultry meat. Braz. J. Microbiol. 2018, 49, 113–118. [Google Scholar] [CrossRef]
- Govind, V.; Bharadwaj, S.; Ganesh, M.R.S.; Vishnu, J.; Shankar, K.V.; Shankar, B.; Rajesh, R. Antiviral properties of copper and its alloys to inactivate COVID-19 virus: A review. BioMetals 2021, 34, 1217–1235. [Google Scholar] [CrossRef]
- Bleichert, P.; Santo, C.E.; Hanczaruk, M.; Meyer, M.; Grass, G. Inactivation of bacterial and viral biothreat agents on metallic copper surfaces. BioMetals 2014, 27, 1179–1189. [Google Scholar] [CrossRef]
- Noyce, J.O.; Michels, H.; Keevil, C.W. Use of Copper Cast Alloys To Control Escherichia coli O157 Cross-Contamination during Food Processing. Appl. Environ. Microbiol. 2006, 72, 4239–4244. [Google Scholar] [CrossRef]
- Wilks, S.A.; Michels, H.; Keevil, C.W. The survival of Escherichia coli O157 on a range of metal surfaces. Int. J. Food Microbiol. 2005, 105, 445–454. [Google Scholar] [CrossRef]
- Weaver, L.; Michels, H.T.; Keevil, C.W. Survival of Clostridium difficile on copper and steel: Futuristic options for hospital hygiene. J. Hosp. Infect. 2008, 68, 145–151. [Google Scholar] [CrossRef]
- Schraufstatter, E.; Bernt, H. Antibacterial Action of Curcumin and Related Compounds. Nature 1949, 164, 456. [Google Scholar] [CrossRef]
- Nelson, K.M.; Dahlin, J.L.; Bisson, J.; Graham, J.; Pauli, G.F.; Walters, M.A. The Essential Medicinal Chemistry of Curcumin. J. Med. Chem. 2017, 60, 1620–1637. [Google Scholar] [CrossRef]
- Adamczak, A.; Ożarowski, M.; Karpiński, T.M. Curcumin, a Natural Antimicrobial Agent with Strain-Specific Activity. Pharmaceuticals 2020, 13, 153. [Google Scholar] [CrossRef]
- Dai, C.; Lin, J.; Li, H.; Shen, Z.; Wang, Y.; Velkov, T.; Shen, J. The Natural Product Curcumin as an Antibacterial Agent: Current Achievements and Problems. Antioxidants 2022, 11, 459. [Google Scholar] [CrossRef] [PubMed]
- Ak, T.; Gülçin, İ. Antioxidant and radical scavenging properties of curcumin. Chem.-Biol. Interact. 2008, 174, 27–37. [Google Scholar] [CrossRef] [PubMed]
- Oves, M.; Rauf, M.A.; Ansari, M.O.; Khan, A.A.P.; Qari, H.A.; Alajmi, M.F.; Sau, S.; Iyer, A.K. Graphene Decorated Zinc Oxide and Curcumin to Disinfect the Methicillin-Resistant Staphylococcus aureus. Nanomaterials 2020, 10, 1004. [Google Scholar] [CrossRef]
- Dolgov, A.; Lopaev, D.; Lee, C. Characterization of carbon contamination under ion and hot atom bombardment in a tin-plasma extreme ultraviolet light source. Appl. Surf. Sci. 2015, 353, 708–713. [Google Scholar] [CrossRef]
- Ansari, M.O.; Kumar, R.; Alshahrie, A.; Abdel-wahab, M.S.; Sajith, V.K.; Ansari, M.S.; Jilani, A.; Barakat, M.A.; Darwesh, R. CuO sputtered flexible polyaniline@graphene thin films:A recyclable photocatalyst with enhanced electrical properties. Compos. Part B Eng. 2019, 175, 107092. [Google Scholar] [CrossRef]
- Akhavan, O.; Ghader, E.; Shirazian, S.A. Near infrared laser stimulation of human neural stem cells into neurons on graphene nanomesh semiconductors. Colloids Surf B Biointerfaces 2015, 126, 313–321. [Google Scholar] [CrossRef]
- Akhavan, O.; Tohidi, H.; Moshfegh, A. Synthesis and electrochromic study of sol–gel cuprous oxide nanoparticles accumulated on silica thin film. Thin Solid Film. 2009, 517, 6700–6706. [Google Scholar] [CrossRef]
- Li, J.; He, M.; Yan, J.; Liu, J.; Zhang, J.; Ma, J. Room Temperature Engineering Crystal Facet of Cu2O for Photocatalytic Degradation of Methyl Orange. Nanomaterials 2022, 12, 1697. [Google Scholar] [CrossRef]
- Ozdal, M.; Gurkok, S. Recent advances in nanoparticles as antibacterial agent. ADMET DMPK 2022, 10, 115–129. [Google Scholar] [CrossRef]
- Ahmad, N.S.; Abdullah, N.; Yasin, F.M. Toxicity assessment of reduced graphene oxide and titanium dioxide nanomaterials on gram-positive and gram-negative bacteria under normal laboratory lighting condition. Toxicol. Rep. 2020, 7, 693–699. [Google Scholar] [CrossRef]
- Culotti, A.; Packman, A.I. Pseudomonas aeruginosa Promotes Escherichia coli Biofilm Formation in Nutrient-Limited Medium. PLoS ONE 2014, 9, e107186. [Google Scholar] [CrossRef]
- Sanni, O.; Chang, C.-Y.; Anderson, D.G.; Langer, R.; Davies, M.C.; Williams, P.M.; Williams, P.; Alexander, M.R.; Hook, A.L. Bacterial Attachment to Polymeric Materials Correlates with Molecular Flexibility and Hydrophilicity. Adv. Healthc. Mater 2015, 4, 695–701. [Google Scholar] [CrossRef]
- Rosenhahn, A.; Schilp, S.; Kreuzerc, H.J.; Grunze, M. The role of “inert” surface chemistry in marine biofouling prevention. Phys. Chem. Chem. Phys. 2010, 12, 4275–4286. [Google Scholar] [CrossRef]
- Hojati, S.T.; Alaghemand, S.; Hamze, H.; Babaki, F.A.; Rajab-Nia, R.; Rezvani, M.B.; Kaviani, M.; Atai, M. Antibacterial, physical and mechanical properties of flowable resin composites containing zinc oxide nanoparticles. Dent. Mater. 2013, 29, 495–505. [Google Scholar] [CrossRef]
- Lai, M.-J.; Huang, Y.-W.; Chen, H.-C.; Tsao, L.-I.; Chien, C.-F.C.; Singh, B.; Liu, B.R. Effect of Size and Concentration of Copper Nanoparticles on the Antimicrobial Activity in Escherichia coli through Multiple Mechanisms. Nanomaterials 2022, 12, 3715. [Google Scholar] [CrossRef]
- Hettiarachchi, S.S.; Perera, Y.; Dunuweera, S.P.; Dunuweera, A.N.; Rajapakse, S.; Rajapakse, M.G.R. Comparison of Antibacterial Activity of Nanocurcumin with Bulk Curcumin. ACS Omega 2022, 7, 46494–46500. [Google Scholar] [CrossRef]
- Wang, L.; Hu, C.; Shao, L. The antimicrobial activity of nanoparticles: Present situation and prospects for the future. Int. J. Nanomed. 2017, 12, 1227–1249. [Google Scholar] [CrossRef]
- Akhavan, O.; Ghaderi, E. Toxicity of Graphene and Graphene Oxide Nanowalls Against Bacteria. ACS Nano 2010, 4, 5731–5736. [Google Scholar] [CrossRef]
- Dutta, T.; Sarkar, R.; Pakhira, B.; Ghosh, S.; Sarkar, R.; Barui, A.; Sarkar, S. ROS generation by reduced graphene oxide (rGO) induced by visible light showing antibacterial activity: Comparison with graphene oxide (GO). RSC Adv. 2015, 5, 80192–80195. [Google Scholar] [CrossRef]
- Prasanna, V.L.; Vijayaraghavan, R. Insight into the Mechanism of Antibacterial Activity of ZnO: Surface Defects Mediated Reactive Oxygen Species Even in the Dark. Langmuir 2015, 31, 9155–9162. [Google Scholar] [CrossRef]
- Li, S.; Zeng, T.H.; Hofmann, M.; Burcombe, E.; Wei, J.; Jiang, R.; Kong, J.; Chen, Y. Antibacterial Activity of Graphite, Graphite Oxide, Graphene Oxide, and Reduced Graphene Oxide: Membrane and Oxidative Stress. ACS Nano 2011, 5, 6971–6980. [Google Scholar] [CrossRef] [PubMed]
- Akhavan, O.; Ghaderi, E. Escherichia coli bacteria reduce graphene oxide to bactericidal graphene in a self-limiting manner. Carbon 2012, 50, 1853–1860. [Google Scholar] [CrossRef]
- Kumar, A.; Pandey, A.K.; Singh, S.S. Engineered ZnO and TiO2 nanoparticles induce oxidative stress and DNA damage leading to reduced viability of Escherichia coli. Free. Radic. Biol. Med. 2011, 51, 1872–1881. [Google Scholar] [CrossRef] [PubMed]
- Wang, Y.-W.; Cao, A.; Jiang, Y.; Zhang, X.; Liu, J.-H.; Liu, Y.; Wang, H. Superior Antibacterial Activity of Zinc Oxide/Graphene Oxide Composites Originating from High Zinc Concentration Localized around Bacteria. ACS Appl. Mater. Interfaces 2014, 6, 2791–2798. [Google Scholar] [CrossRef]
- Jannesari, M.; Akhavan, O.; Hosseini, H.R.M.; Bakhshi, B. Graphene/CuO2 Nanoshuttles with Controllable Release of Oxygen Nanobubbles Promoting Interruption of Bacterial Respiration. ACS Appl. Mater. Interfaces 2020, 12, 35813–35825. [Google Scholar] [CrossRef]
- Khan, A.; Rashid, A.; Younas, R.; Chong, R. A chemical reduction approach to the synthesis of copper nanoparticles. Int. Nano Lett. 2015, 6, 21–26. [Google Scholar] [CrossRef]
- Marcano, D.C.; Kosynkin, D.V.; Berlin, J.M.; Sinitskii, A.; Sun, Z.; Slesarev, A.; Alemany, L.B.; Lu, W.; Tour, J.M. Improved Synthesis of Graphene Oxide. ACS Nano 2010, 4, 4806–4814. [Google Scholar] [CrossRef]

Disclaimer/Publisher’s Note: The statements, opinions and data contained in all publications are solely those of the individual author(s) and contributor(s) and not of MDPI and/or the editor(s). MDPI and/or the editor(s) disclaim responsibility for any injury to people or property resulting from any ideas, methods, instructions or products referred to in the content. |
© 2023 by the authors. Licensee MDPI, Basel, Switzerland. This article is an open access article distributed under the terms and conditions of the Creative Commons Attribution (CC BY) license (https://creativecommons.org/licenses/by/4.0/).
Share and Cite
Oves, M.; Ansari, M.O.; Ansari, M.S.; Memić, A. Graphene@Curcumin-Copper Paintable Coatings for the Prevention of Nosocomial Microbial Infection. Molecules 2023, 28, 2814. https://doi.org/10.3390/molecules28062814
Oves M, Ansari MO, Ansari MS, Memić A. Graphene@Curcumin-Copper Paintable Coatings for the Prevention of Nosocomial Microbial Infection. Molecules. 2023; 28(6):2814. https://doi.org/10.3390/molecules28062814
Chicago/Turabian StyleOves, Mohammad, Mohammad Omaish Ansari, Mohammad Shahnawaze Ansari, and Adnan Memić. 2023. "Graphene@Curcumin-Copper Paintable Coatings for the Prevention of Nosocomial Microbial Infection" Molecules 28, no. 6: 2814. https://doi.org/10.3390/molecules28062814
APA StyleOves, M., Ansari, M. O., Ansari, M. S., & Memić, A. (2023). Graphene@Curcumin-Copper Paintable Coatings for the Prevention of Nosocomial Microbial Infection. Molecules, 28(6), 2814. https://doi.org/10.3390/molecules28062814

